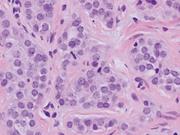
featured image

Issue navigation
Volume 2013, Issue 4, April 2013
Case Reports
Cholecystogastric fistula: a brief report and review of the literature
Michael R. Boland and others
Journal of Surgical Case Reports, Volume 2013, Issue 4, April 2013, rjt028, https://doi.org/10.1093/jscr/rjt028
Repair of a complex post-EVAR type III endoleak using a chimney aortouniiliac stent graft and femorofemoral crossover bypass
Jack Kian Ch'ng and others
Journal of Surgical Case Reports, Volume 2013, Issue 4, April 2013, rjt027, https://doi.org/10.1093/jscr/rjt027
Incarcerated and perforated stomach found in parastomal hernia: a case of a stomach in a parastomal hernia and subsequent strangulation-induced necrosis and perforation
Anne K. Marsh and Martin Hoejgaard
Journal of Surgical Case Reports, Volume 2013, Issue 4, April 2013, rjt029, https://doi.org/10.1093/jscr/rjt029
An unusual case of a pituitary fossa aspergilloma in an immunocompetent patient mimicking infiltrative tumour
Hasib Ahmadzai and others
Journal of Surgical Case Reports, Volume 2013, Issue 4, April 2013, rjt018, https://doi.org/10.1093/jscr/rjt018
Accelerated healing of complex open pilonidal wounds using MatriStem extracellular matrix xenograft: nine cases
Kent C. Sasse and others
Journal of Surgical Case Reports, Volume 2013, Issue 4, April 2013, rjt025, https://doi.org/10.1093/jscr/rjt025
Biological mesh repair of a strangulated perineal hernia following abdominoperineal resection
Simon A. Fallis and others
Journal of Surgical Case Reports, Volume 2013, Issue 4, April 2013, rjt023, https://doi.org/10.1093/jscr/rjt023
An incidental finding of carcinoid tumor of the cystic duct
Hoang U. Lim and others
Journal of Surgical Case Reports, Volume 2013, Issue 4, April 2013, rjt021, https://doi.org/10.1093/jscr/rjt021
Can release of urinary retention trigger abdominal aortic aneurysm rupture?
Andreas Luhmann and others
Journal of Surgical Case Reports, Volume 2013, Issue 4, April 2013, rjt019, https://doi.org/10.1093/jscr/rjt019
Pancreatic sarcoidosis discovered during Whipple procedure
Jonathan Cook and others
Journal of Surgical Case Reports, Volume 2013, Issue 4, April 2013, rjt016, https://doi.org/10.1093/jscr/rjt016
Advertisement
Advertisement